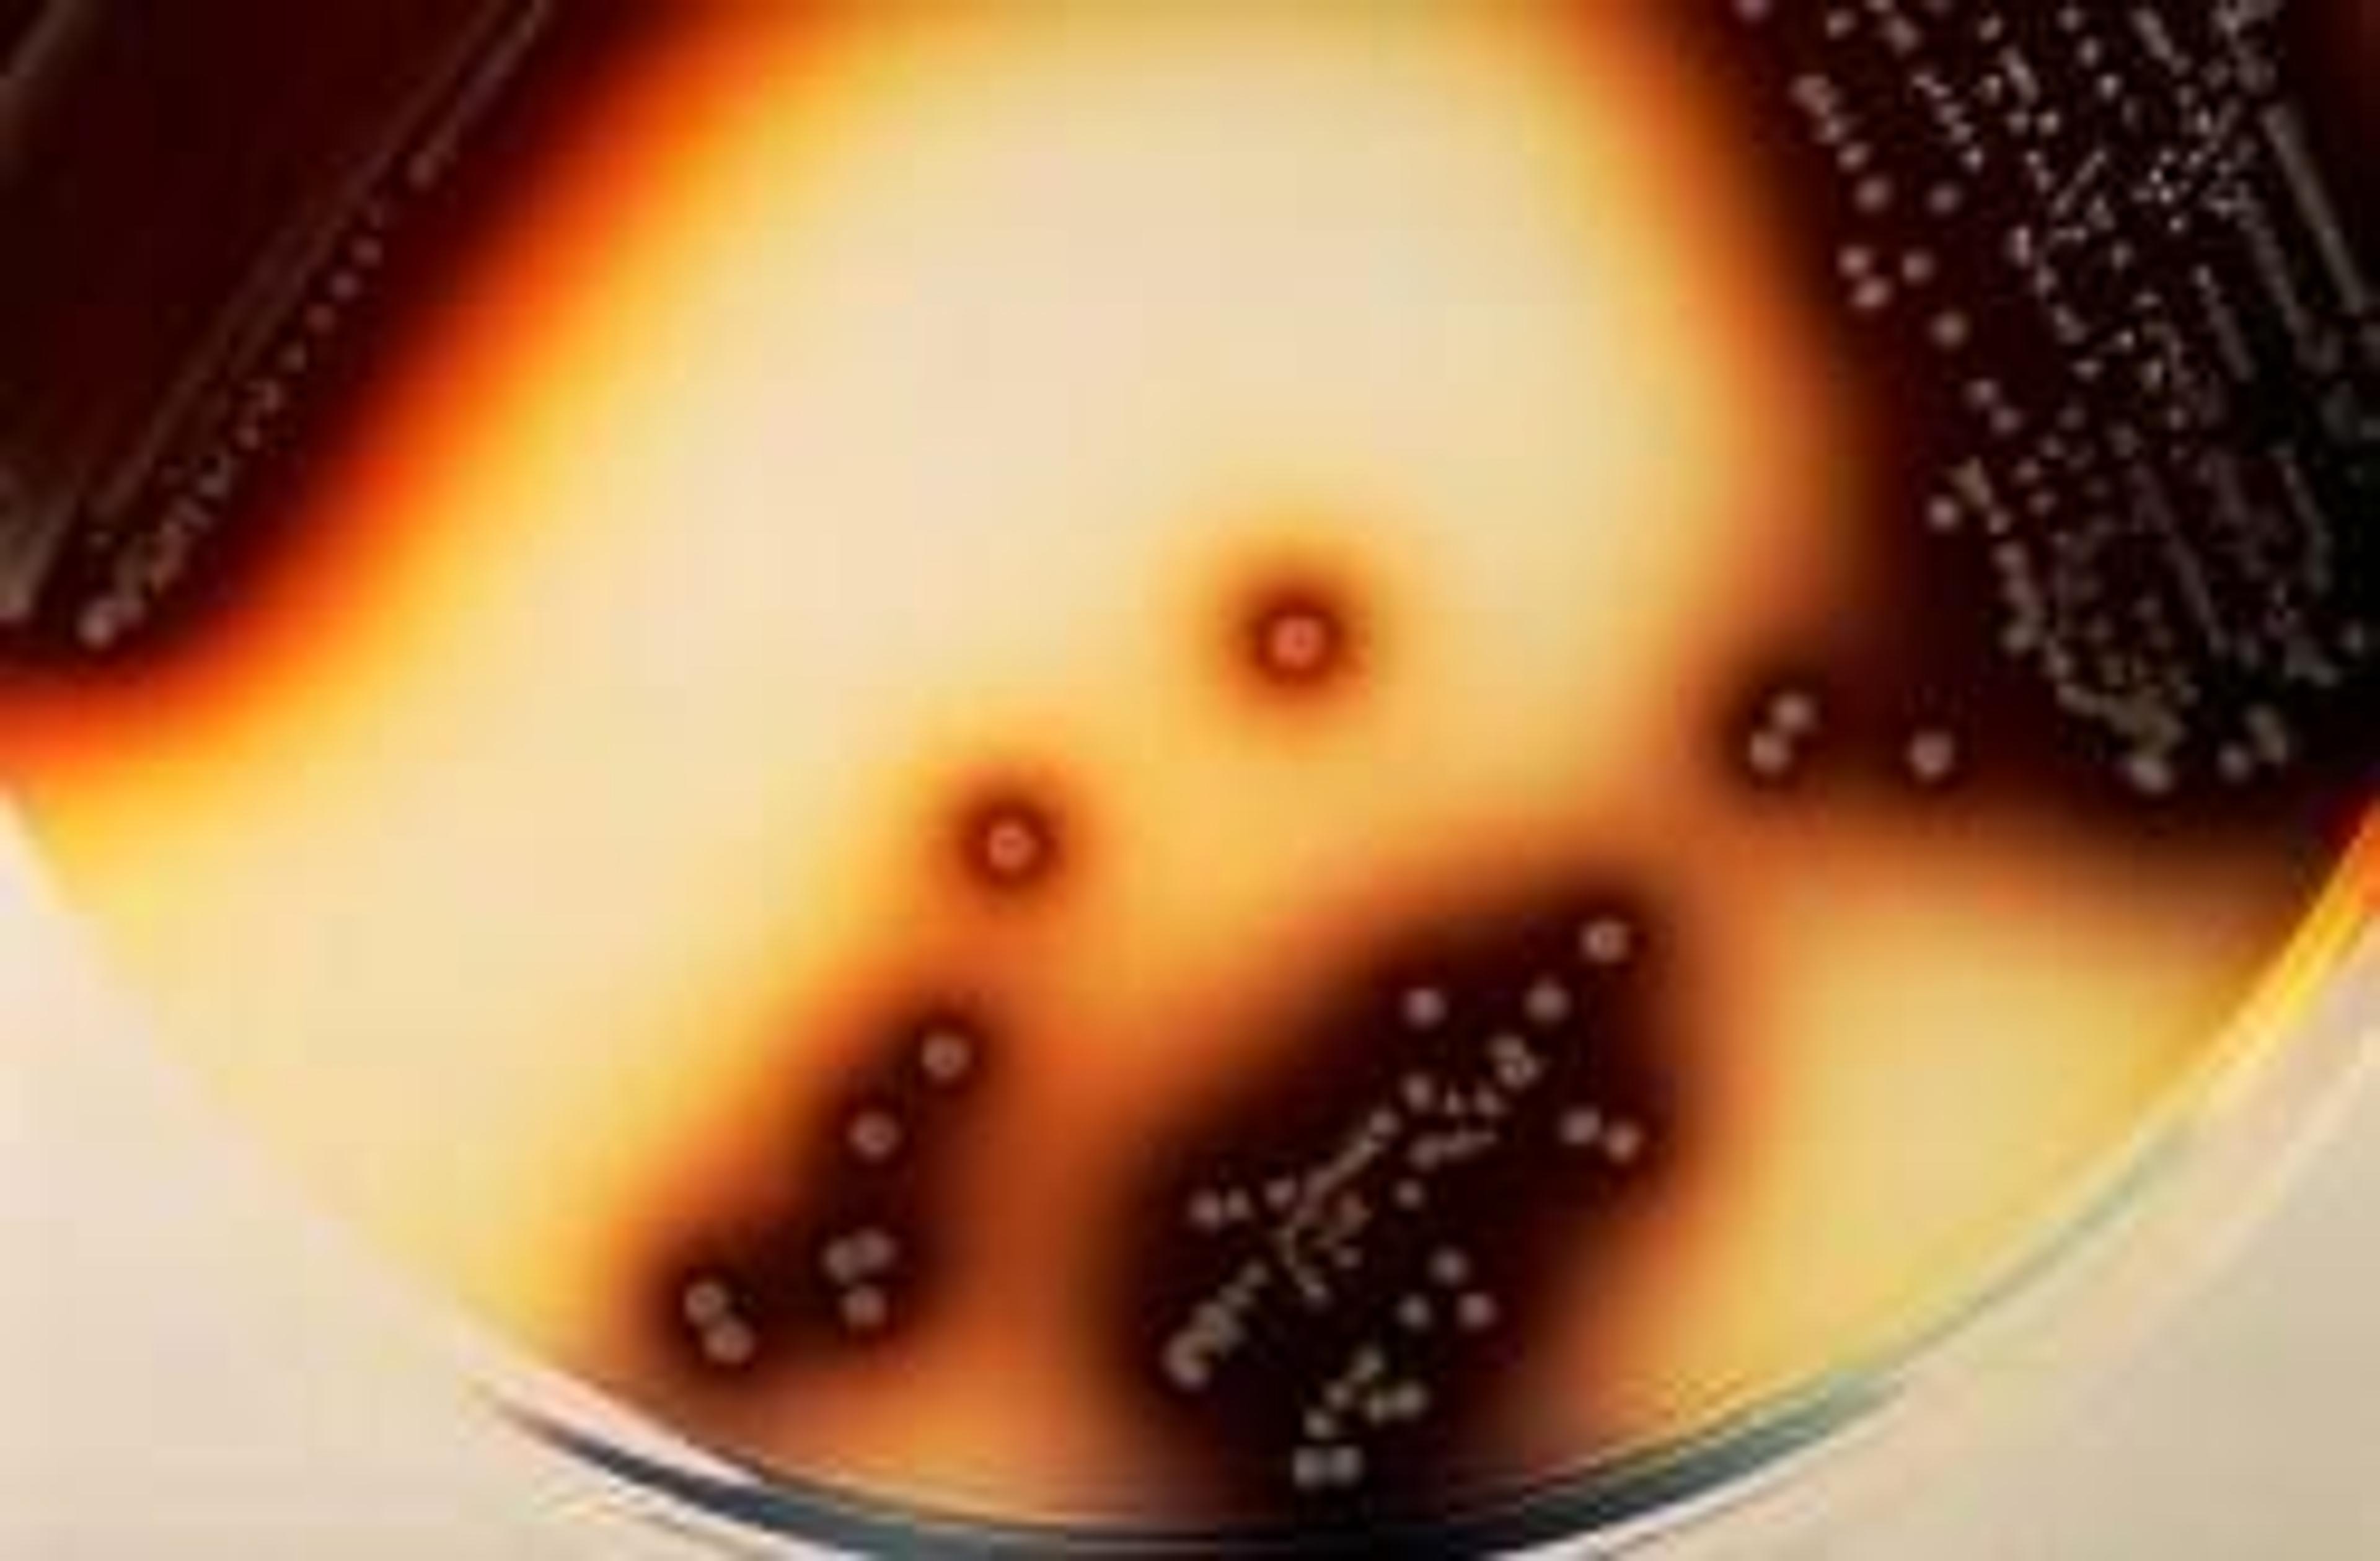

Search results for "molecular microbiology"
Selected Filters:
Gradientech Previews QuickMIC, an Ultra-Rapid IVD System for AST at ECCMID 2019
New system promises to deliver antibiotic susceptibility testing results in two hours to help avoid misuse of antibiotics in suspected sepsis patients
SEAL Analytical Acquires Lab Automation Specialist
New Automated and Compact Pourer Stacker APS
Size Exclusion Chromatography (SEC) Column for mAb Separations
YMC EuropeYMC-SEC MAB is a silica-based size exclusion chromatography column utilizing a dihydroxypropyl stationary phase bonded to a silica gel base, specifically designed for antibody separations.
How to minimize the risk of food fraud due to coronavirus
Watch this on-demand webinar to gain insights into the new risks for food fraud due to coronavirus and how they can be mitigated
Whole-town study reveals more than 40% of COVID-19 infections had no symptoms
A study of COVID-19 in the quarantined Italian town of Vò, where most of the population was tested, reveals the importance of asymptomatic cases
The latest innovations in cancer research from AACR 2023: Liquid biopsies, spatial technologies, companion diagnostics and more
Explore the latest advances in cancer research from a focal event in the cancer community calendar
‘The basic foundation for science is transparent and open communication’
Dr. Vikramsingh Gujar, from Northwestern University, discusses his research on inflammatory disorders and why effective knowledge share is vital for scientific advancement
Using a menthol-like compound to activate plant immune mechanisms
A menthol-like compound was found to boost the expression of genes that protect crop species from pest-related damage
Beckman Coulter MicroScan wins IMV ServiceTrak Best System Performance at AACC
The MicroScan WalkAway family of instruments was presented with the award for the second year in a row
New Diagnostic Test Helps Hospitals Identify and Treat Emerging Antibiotic-Resistant Bacteria
Fully-automated BD Phoenix™ CPO Detect Test Receives U.S. FDA Clearance